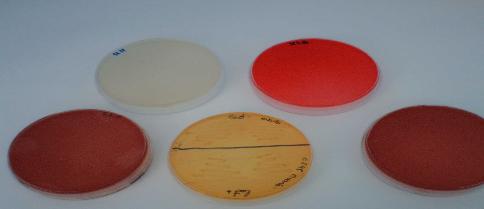

Inmunología
Inmunoprofilaxis mediante elaboración de autovacunas.
Elaboración de inmunopreparado vacunal frente a las patologías en las que son recomendables y posibles. Por ejemplo:
Papilomavirus, Actinobacilus pleuropneumoniae, Arcanobacterium pyogenes, Haemophylus parasuis, Erysipelotrix rhusiopathiae, Mannhemimia Haemolytica, Pasteurella spp, Moraxella spp, Streptococcus spp, Staphylococcus spp, ...